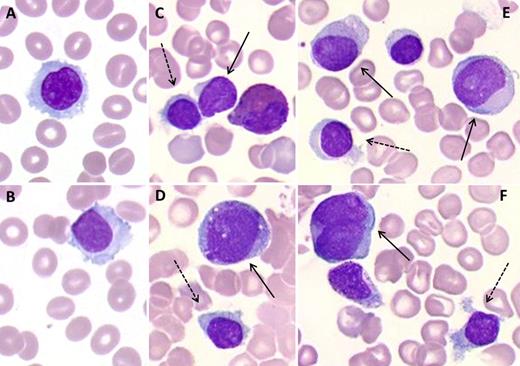
An 82-year-old man without history of hematologic or malignant disorders was admitted for fatigue. The complete blood count showed bicytopenia: a macrocytic anemia (10.6 g/dL, 101.3 fL, and 33 × 109/L reticulocytes), leukopenia (2 × 109/L) with neutropenia (0.2 × 109/L), monocytopenia (0.04 × 109/L), and 171 × 109/L platelets. The peripheral smear showed 8% small- to medium-sized hairy lymphocytes with an oval nucleus and pale blue cytoplasm (panels A-B) highly suggestive of hairy cell leukemia. Immunophenotyping of peripheral blood (PB) showed 11% κ-restricted B lymphocytes expressing CD11c but lacking CD24, CD25, CD103, and CD123, consistent with a splenic marginal zone lymphoma. Indeed, the bone marrow (BM) smear showed 10.5% abnormal lymphocytes, with a villous (not hairy cell) morphology (panels C-F, dotted arrows) and the same immunophenotype as the PB cells. The BM had decreased cellularity, with 20% blasts present (panels C-F, full arrows) together with maturing cells of the neutrophil lineage and dyserythropoiesis. Cytochemistry confirmed the positivity of blasts for myeloperoxidase, leading to the diagnosis of acute myeloid leukemia. / Conventional cytogenetics of the myeloid blasts detected a complex karyotype with del(5q). Treatment with azacytidine was started. This observation of cytopenia led to the rare and unexpected diagnosis of 2 hematologic neoplasms: splenic marginal zone lymphoma and acute myeloid leukemia with maturation.

An 82-year-old man without history of hematologic or malignant disorders was admitted for fatigue. The complete blood count showed bicytopenia: a macrocytic anemia (10.6 g/dL, 101.3 fL, and 33 × 109/L reticulocytes), leukopenia (2 × 109/L) with neutropenia (0.2 × 109/L), monocytopenia (0.04 × 109/L), and 171 × 109/L platelets. The peripheral smear showed 8% small- to medium-sized hairy lymphocytes with an oval nucleus and pale blue cytoplasm (panels A-B) highly suggestive of hairy cell leukemia. Immunophenotyping of peripheral blood (PB) showed 11% κ-restricted B lymphocytes expressing CD11c but lacking CD24, CD25, CD103, and CD123, consistent with a splenic marginal zone lymphoma. Indeed, the bone marrow (BM) smear showed 10.5% abnormal lymphocytes, with a villous (not hairy cell) morphology (panels C-F, dotted arrows) and the same immunophenotype as the PB cells. The BM had decreased cellularity, with 20% blasts present (panels C-F, full arrows) together with maturing cells of the neutrophil lineage and dyserythropoiesis. Cytochemistry confirmed the positivity of blasts for myeloperoxidase, leading to the diagnosis of acute myeloid leukemia.
Conventional cytogenetics of the myeloid blasts detected a complex karyotype with del(5q). Treatment with azacytidine was started. This observation of cytopenia led to the rare and unexpected diagnosis of 2 hematologic neoplasms: splenic marginal zone lymphoma and acute myeloid leukemia with maturation.
An 82-year-old man without history of hematologic or malignant disorders was admitted for fatigue. The complete blood count showed bicytopenia: a macrocytic anemia (10.6 g/dL, 101.3 fL, and 33 × 109/L reticulocytes), leukopenia (2 × 109/L) with neutropenia (0.2 × 109/L), monocytopenia (0.04 × 109/L), and 171 × 109/L platelets. The peripheral smear showed 8% small- to medium-sized hairy lymphocytes with an oval nucleus and pale blue cytoplasm (panels A-B) highly suggestive of hairy cell leukemia. Immunophenotyping of peripheral blood (PB) showed 11% κ-restricted B lymphocytes expressing CD11c but lacking CD24, CD25, CD103, and CD123, consistent with a splenic marginal zone lymphoma. Indeed, the bone marrow (BM) smear showed 10.5% abnormal lymphocytes, with a villous (not hairy cell) morphology (panels C-F, dotted arrows) and the same immunophenotype as the PB cells. The BM had decreased cellularity, with 20% blasts present (panels C-F, full arrows) together with maturing cells of the neutrophil lineage and dyserythropoiesis. Cytochemistry confirmed the positivity of blasts for myeloperoxidase, leading to the diagnosis of acute myeloid leukemia.
Conventional cytogenetics of the myeloid blasts detected a complex karyotype with del(5q). Treatment with azacytidine was started. This observation of cytopenia led to the rare and unexpected diagnosis of 2 hematologic neoplasms: splenic marginal zone lymphoma and acute myeloid leukemia with maturation.
For additional images, visit the ASH IMAGE BANK, a reference and teaching tool that is continually updated with new atlas and case study images. For more information visit http://imagebank.hematology.org.